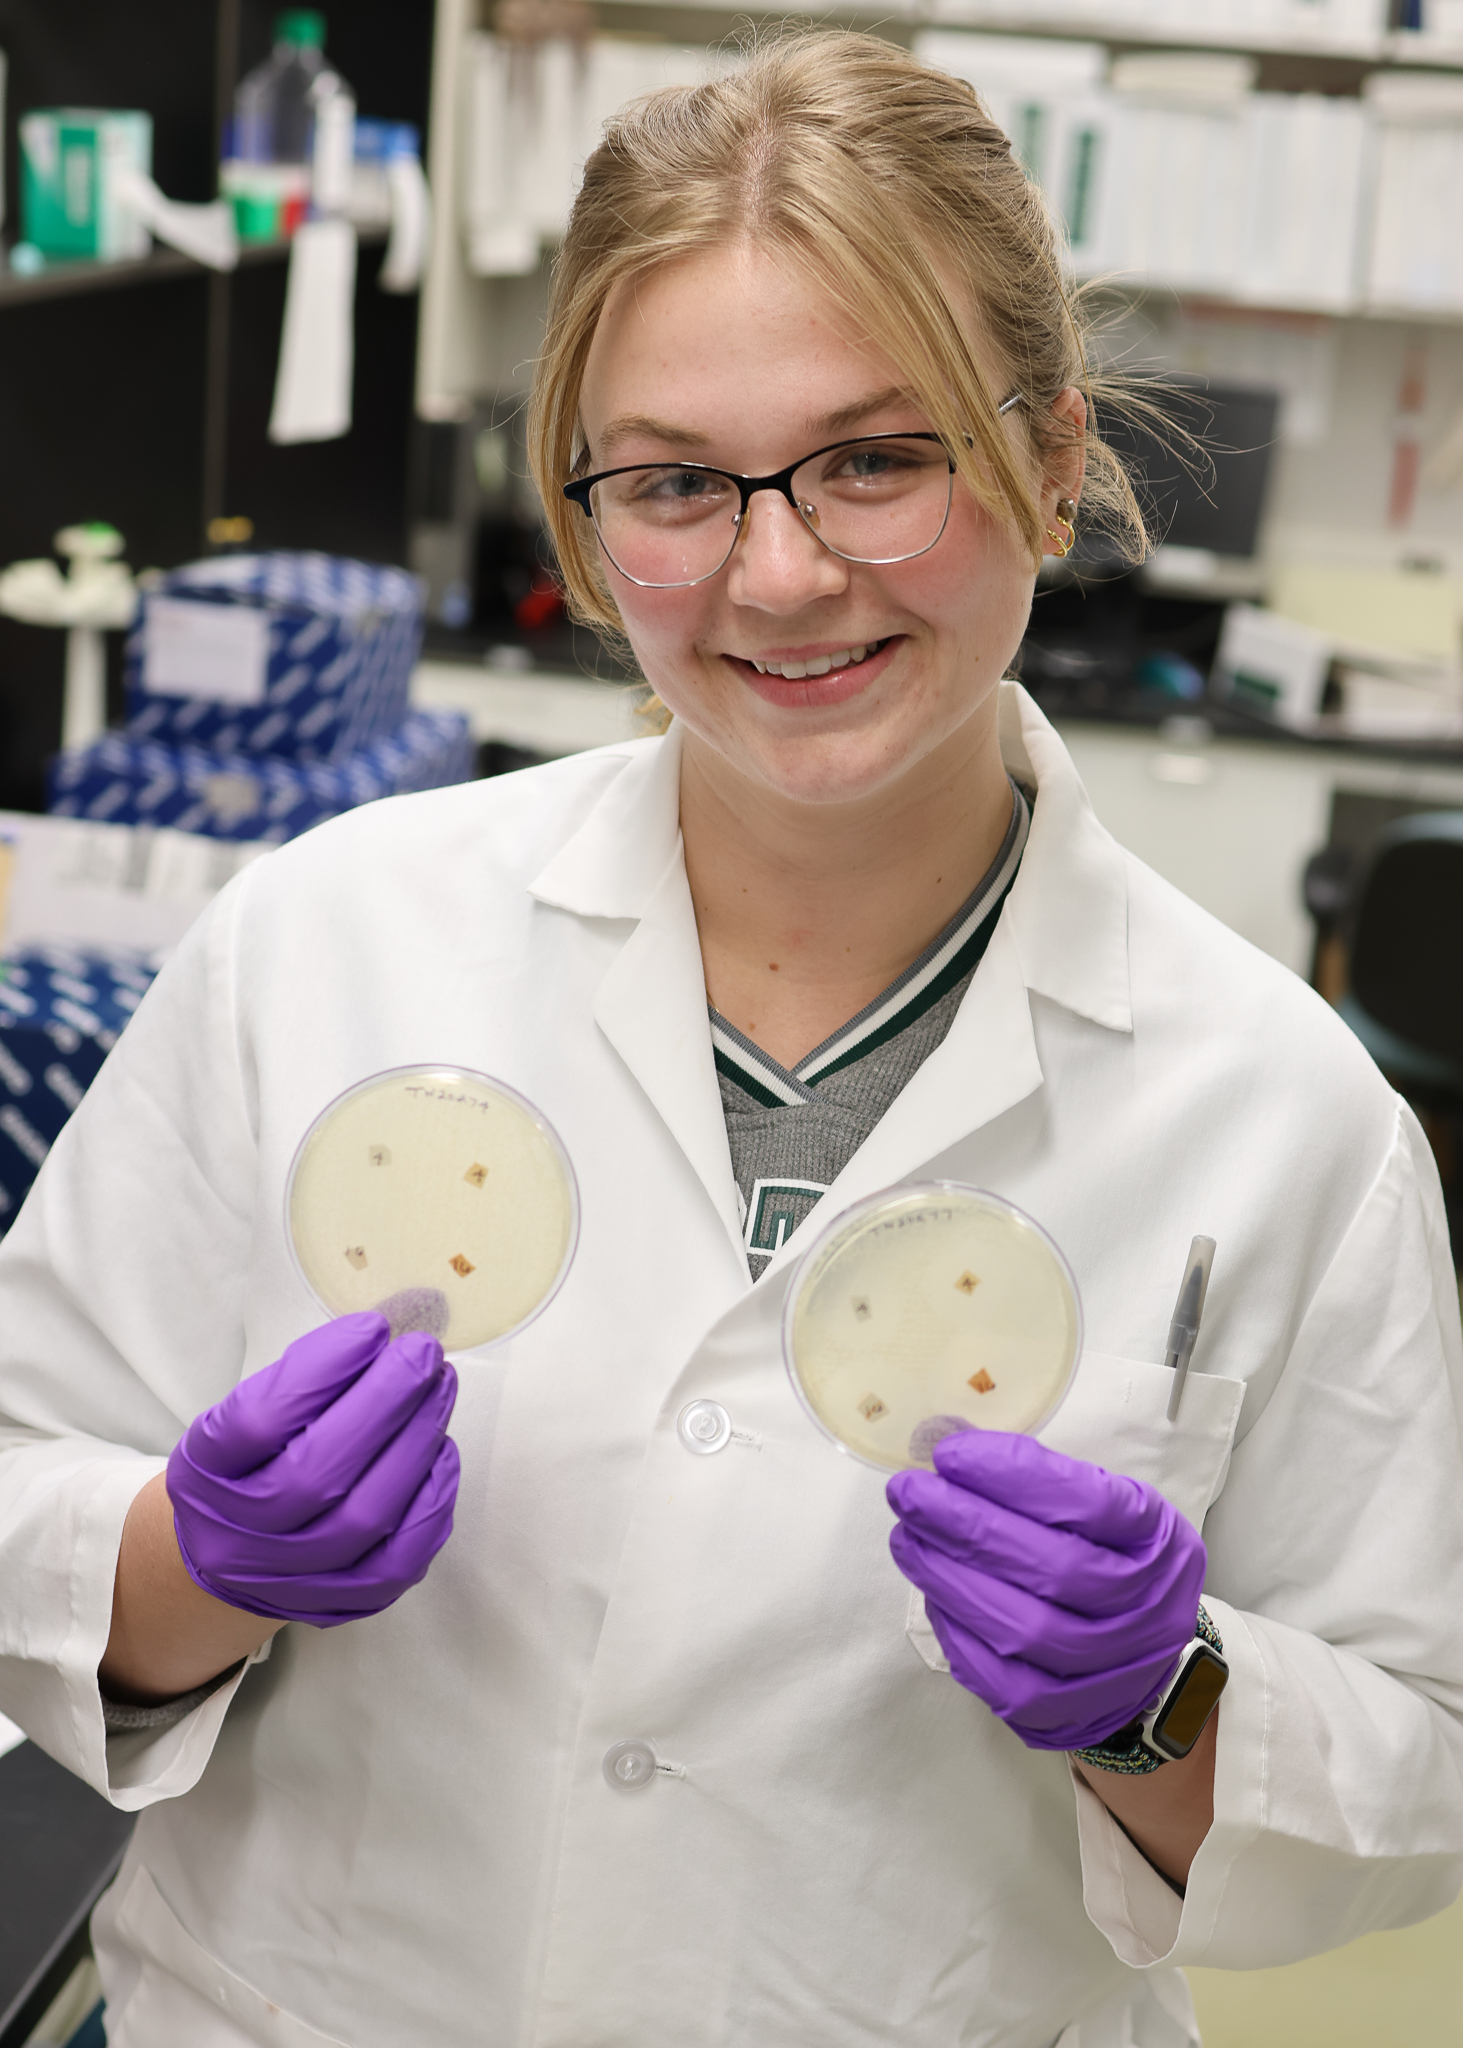

MGI doctoral students awarded prestigious APHL-CDC fellowships
Two MGI doctoral students, Danielle Gregory and Kyleen Hall, have been awarded prestigious fellowships from the Public Health Laboratory Fellowship Program. The program is an initiative by the Association of Public Health Laboratories, or APHL, and the Centers for Disease Control and Prevention, or CDC.
The APHL-CDC Public Health Laboratory Fellowship is a highly competitive program that provides funding and professional development opportunities for emerging public health professionals. The fellowship includes a stipend, funds for attending conferences, and resources for research projects. This year, the APHL annual conference will be held in Portland, Oregon, where both students will present their research.
Both Gregory and Hall work in Shannon Manning’s lab, and their work focuses on antibiotic resistance.
Danielle Gregory's research focuses on antibiotic resistance in Michigan dairy cows, specifically examining the impact of third-generation cephalosporins on the emergence of resistant bacteria and the likelihood of those bacteria transferring to either humans working with the cows or to other animals on the farm.
“This research is important because animal and human and environmental health are all linked,” said Gregory. “So, only studying the impacts of antibiotic usage on one sector really doesn’t give us a total picture of the likelihood, specifically for antibiotic resistance, of the transfer between those environments.”

Gregory expressed her gratitude for the fellowship, noting that it provides valuable non-academic experiences and opportunities to collaborate with various microbiology agencies in Michigan.
"For example, for my project, it allows me to partner both with the Veterinary Diagnostic Lab as well as the Michigan Department of Health and Human Services and to really bring in the expertise of the people in both of those labs,” said Gregory. “And for my project to be able to make a fully ‘One Health’ project, getting to talk to experts in both animal and human health and combining the research aspect is what I wanted to do, so it’s been excellent for that purpose.”
Kyleen Hall's project investigates antibiotic resistance in clinical isolates of Shigella, a bacterium that causes dysentery. She is tracking the prevalence and temporality of resistant infections in Michigan.
Monitoring antibiotic resistance in foodborne pathogens like Shigella is crucial, according to Hall. However, the CDC’s surveillance efforts can sometimes lack accuracy due to the varying nature of sample collection and receipt. “Accurate surveillance is really important because it informs decisions when it comes to research and when it comes to options for treatment,” said Hall. “And so, if we don’t have accurate surveillance, we often see negative side effects.”
Hall credits the fellowship with helping her understand what her future public health career options might be.
“I knew that I wanted to go into this field, and I knew I wanted to work for the government, but I really had no idea what that would look like or what I would be doing,” said Hall. “The fellowship has been so helpful with figuring out how the public health labs and public health system work and where I could potentially see myself fitting into that.”
Both students emphasized the importance of accurate surveillance and interdisciplinary collaboration in addressing public health challenges. Their work highlights the critical link between animal, human, and environmental health, and the need for comprehensive approaches to combat antibiotic resistance.
"I am so proud of Danielle and Kyleen for receiving these highly competitive fellowships to pursue their research on topics that are important for public health,” said Shannon Manning, MSU Research Foundation Professor in the department of Microbiology, Genetics, & Immunology. “Both are outstanding researchers and are highly deserving of this recognition.
“We are grateful to the APHL-CDC for supporting their projects and providing them with valuable training and networking opportunities to help them prepare for future careers in clinical microbiology and public health."



